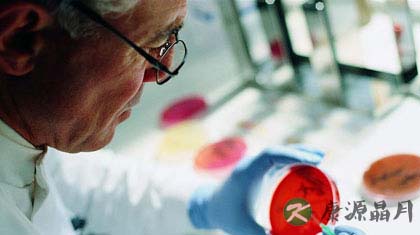
白血病会隔代遗传吗

- 您好!欢迎来到康源名医金桥网

小编导读:白血病会隔代遗传吗?白血病,又称“血癌”,是一种恶性程度极高的血液病。白血病会隔代遗传吗?下面一起来看看专家怎么说吧。
白血病是一类造血干细胞恶性克隆性疾病。克隆性白血病细胞因为增殖失控、分化障碍、凋亡受阻等机制在骨髓和其他造血组织中大量增殖累积,并浸润其他组织和器官,同时正常造血受抑制。临床可见不同程度的贫血、出血、感染发热以及肝、脾、淋巴结肿大和骨骼疼痛。据报道,我国各地区白血病的发病率在各种肿瘤中占第六位。
白血病会隔代遗传吗
早在100多年前,已提出在人类白血病在发病中遗传因素可能起着一定作用。经研究证实,遗传因素、染色体以及基因异常之间具有密切联系。某些白血病的发生与遗传因素有关,证据如下:
(1)在单合子双生“同卵双生”中,一人患白血病,另一人患白血病的机会约为20%~25%,比双合子孪生(双卵双生)者高12倍,其白血病类型主要是急性淋巴细胞白血病和急性粒细胞白血病。
(2)在白血病患者的兄弟姐妹间,白血病的发病率比自然人群中高约2~4倍“10/10万”,其类型也主要为急性淋巴细胞白血病和急性粒细胞白血病。
白血病的确切病因尚不明确,一般认为病毒感染、X射线、γ射线等电离辐射因素、化学因素、遗传因素有关。白血病不是遗传病,但具有一定的遗传易感性。有白血病家族史的人患有某些类型白血病的几率比正常人要高,在相同诱因情况下有白血病家族史的人发生白血病的几率较正常人要高。
也就是说白血病一般是不会遗传的,但也不能排除有一定的遗传倾向,如在一家人中可出现两名以上的白血病病人,也有报道在单卵双生子中两人都患白血病的机会是20%,较双卵双生子的发病率高出12倍,但这种现象也不是普遍现象,并没有一定规律,故很难说白血病一定有遗传性。
专家介绍说,不应该把一切的目光都停留到“白血病会隔代遗传吗”这个问题上,而要更注重于防备。并非一切的白血病都有遗传倾向性,但临床上确见到某些白血病在某一人种(如白种人)、某些遗传性缺点(如Ih,wn氏综合征)和某些宗族性疾病(如Fzlnco山贫血)中较容易发生。同卵双生中,若一人患急性白血病,则另一人患急性白血病的机率(25%)明显高于普通人(5/10万)。以上均提示某些遗传要素能够会对白血病发病产生影响。
不论白血病会不会隔代遗传,都要给自个养成一个良好的生活环境,让白血病离咱们远去,关于现已患上白血病的患者来讲,活跃的承受医治才是走向恢复的唯一路径。
那么诱发白血病的原因有哪些呢?下面一起来看看诱发白血病的原因,在生活中应尽量避免。
诱发白血病的原因
1、病毒因素
RNA病毒在鼠、猫、鸡和牛等动物的致白血病作用已经肯定,这类病毒所致的白血病多属于T细胞型。
2、化学因素
一些化学物质有致白血病的作用。接触苯及其衍生物的人群白血病发生率高于一般人群。亦有亚硝胺类物质、保泰松及其衍生物、氯霉素等诱发白血病的报道。某些抗肿瘤细胞毒药物,如氮芥、环磷酰胺、甲基苄肼、VP16、VM26等都有致白血病作用。

3、放射因素
有证据显示,各种电离辐射可以引起人类白血病。白血病的发生取决于人体吸收辐射的剂量,整个身体或部分躯体受到中等剂量或大剂量辐射后都可诱发白血病。小剂量辐射能否引起白血病仍不确定。经常接触放射线物质(如钴-60)者白血病发病率明显增加。大剂量放射线诊断和治疗可使白血病发生率增高。
4、遗传因素
有染色体畸变的人群白血病发病率高于正常人。
由于白血病分型和预后分层复杂,因此没有千篇一律的治疗方法,需要结合细致的分型和预后分层制定治疗方案。目前主要有下列几类治疗方法,如化学治疗﹑放射治疗﹑靶向治疗、免疫治疗、干细胞移植等。通过合理的综合性治疗,白血病预后得到极大的改观,相当多的患者可以获得治愈或者长期稳定,白血病是“不治之症”的时代过去了。
 豫公网安备 41110202000246号互联网药品信息服务资格证书:(豫)-经营性-2022-0039增值电信业务经营许可证:豫B2-20221313医疗器械经营备案编号:豫郑食药监械经营备20212188号
豫公网安备 41110202000246号互联网药品信息服务资格证书:(豫)-经营性-2022-0039增值电信业务经营许可证:豫B2-20221313医疗器械经营备案编号:豫郑食药监械经营备20212188号




